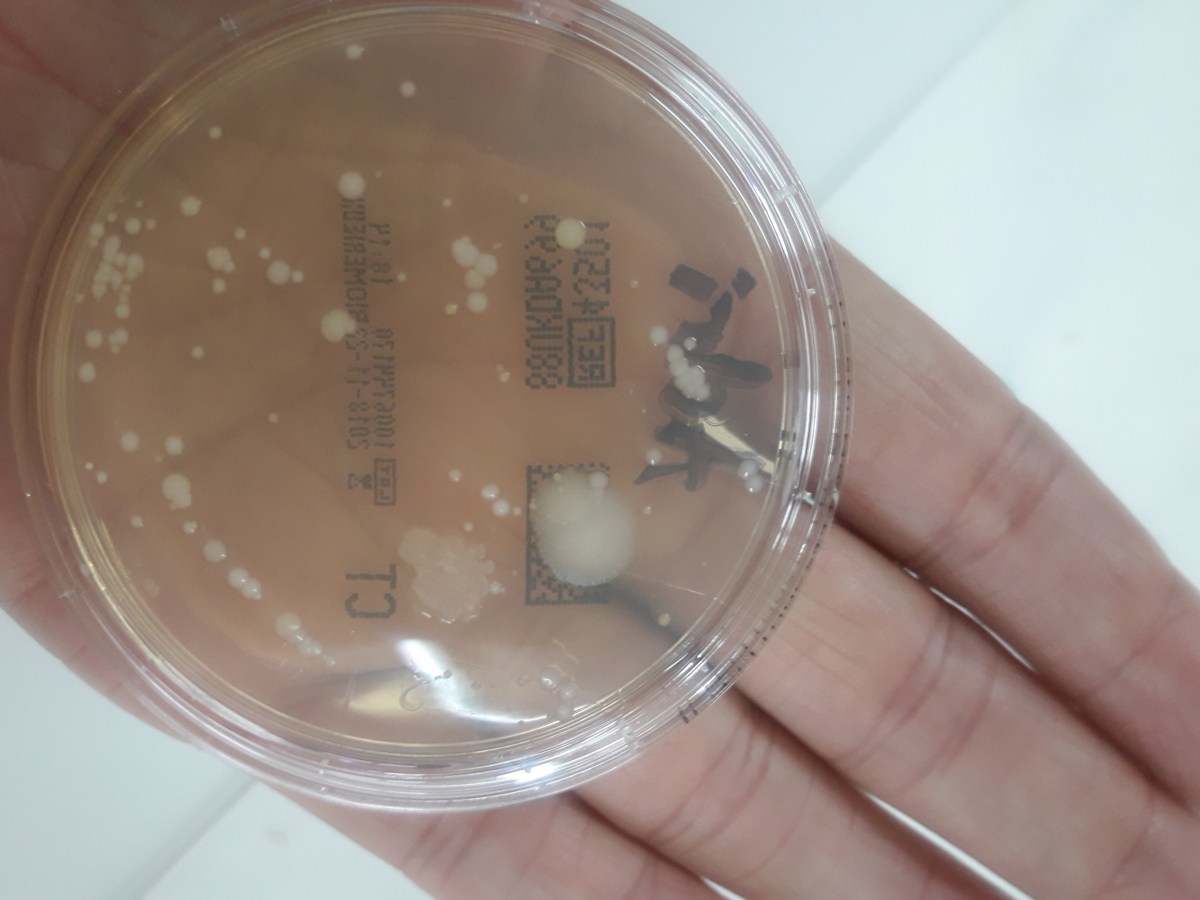

La profe de Bio

El blog de Carlos Pazos. Grafismos, viñetas de humor sobre ciencia, tecnología y todo lo que mola saber.
Un blog gestionado por el Departamento de Biología y Geología del IES Mata Jove
Divulgando ciencia por naturaleza
Ciencias biosanitarias
Blog Cultura Cientifica